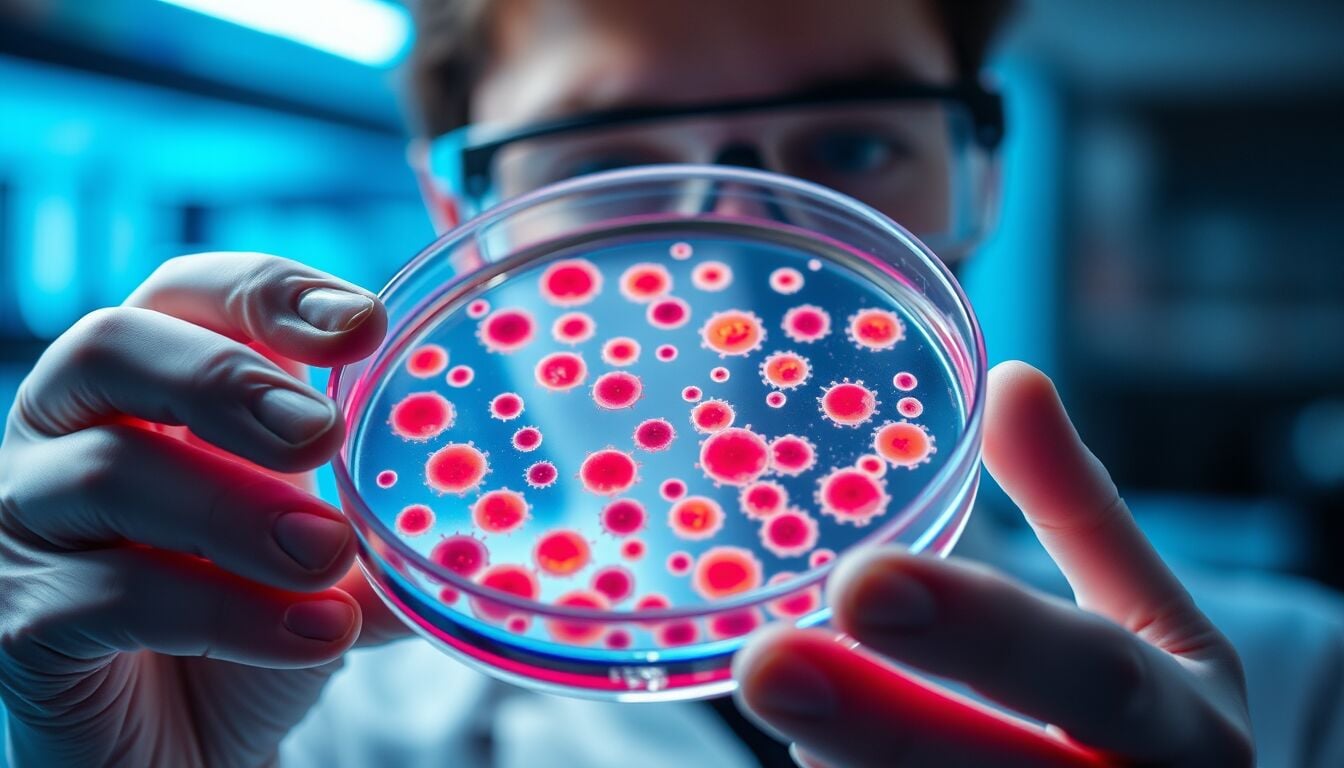
Meningite B in Gran Bretagna, scienziati indagano possibile super ceppo dietro crescita anomala dei casi

About Michele Ficara Manganelli ✿∴♛🌿🇨🇭
Storico esperto di Digital Journalism e creatore di Immediapress la prima Digital Forwarding Agency italiana poi ceduta al Gruppo ADNkronos, evangelista di Internet dai tempi di Mozilla e poi antesignano (ora pentito) dei social media in italia, Bitcoiner Evangelist, portatore sano di Ethereum e Miner di crypto da tempi non sospetti. Sono a dir poco un entusiasta della vita, e già questo non è poco. Intimamente illuminato dalla Cultura Life-Hacking, nonchè per sempre ed indissolubilmente Geek, giocosamente Runner e olisticamente golfista. #senzatimore è da decenni il mio hashtag e significa il coraggio di affrontare l'ignoto. Senza Timore. Appunto
Latest Articles
Ripple amplia la presenza in Brasile con soluzioni digitali integrate per banche tradizionali e nuove fintech
BLOCKCHAIN
Ripple accelera in Brasile con nuova piattaforma cripto regolamentata La società blockchain Ripple, nota per il network XRP Ledger, rafforza…
Maestro presenta Mezzamine nuova soluzione di credito Bitcoin per investitori istituzionali e grandi operatori finanziari
BLOCKCHAIN
Mezzamine, nuovo mercato del credito Bitcoin per istituzioni e miner La società infrastrutturale per Bitcoin Maestro ha lanciato Mezzamine, un…
PayPal espande la stablecoin PYUSD a decine di nuovi mercati globali
BLOCKCHAIN
PayPal estende PYUSD in 70 Paesi e punta sui pagamenti globali La stablecoin PYUSD di PayPal entra in una nuova…
Moody’s rivoluziona le valutazioni creditizie digitali integrandole sulla blockchain tramite Canton Network
BLOCKCHAIN
Moody’s porta i rating onchain e accelera la finanza istituzionale digitale L’agenzia di rating americana Moody’s entra nella blockchain integrando…
Trump conquista l’attenzione politica con la reazione alla morte di Robert Mueller, volto del Russiagate
NEWS
La morte di Robert Mueller riapre la ferita politica del Russiagate La scomparsa di Robert Mueller, ex direttore dell’Fbi e…
Meningite B in Gran Bretagna, scienziati indagano possibile super ceppo dietro crescita anomala dei casi
NEWS
Meningite da meningococco B nel Kent: cosa sappiamo del possibile “super ceppo” Nella contea del Kent, nel Regno Unito, un…
Soccorritori in Alto Adige al lavoro dopo valanga sulla cima Hohe Ferse
NEWS
Valanga sulla Hohe Ferse in Alto Adige: bilancio, vittime e soccorsi Due persone sono morte e cinque sono rimaste ferite,…
Valanga Alto Adige travolge gruppo di scialpinisti: bilancio drammatico tra vittime e feriti
NEWS
Valanga in Val Ridanna: bilancio, vittime e indagini sulle cause Una valanga di grandi dimensioni ha travolto oggi 25 scialpinisti…
Idf avverte sulla capacità dei missili iraniani di colpire Roma e Parigi
NEWS
Missili iraniani in grado di colpire Roma, Parigi e Berlino secondo Israele Il capo di stato maggiore delle Forze di…
Israele prepara nuova fase del conflitto con l’Iran, offensiva destinata a protrarsi ancora a lungo
NEWS
Israele annuncia settimane di guerra contro Iran e intensificazione in Libano Un alto funzionario politico israeliano, citato da Ynet, ha…